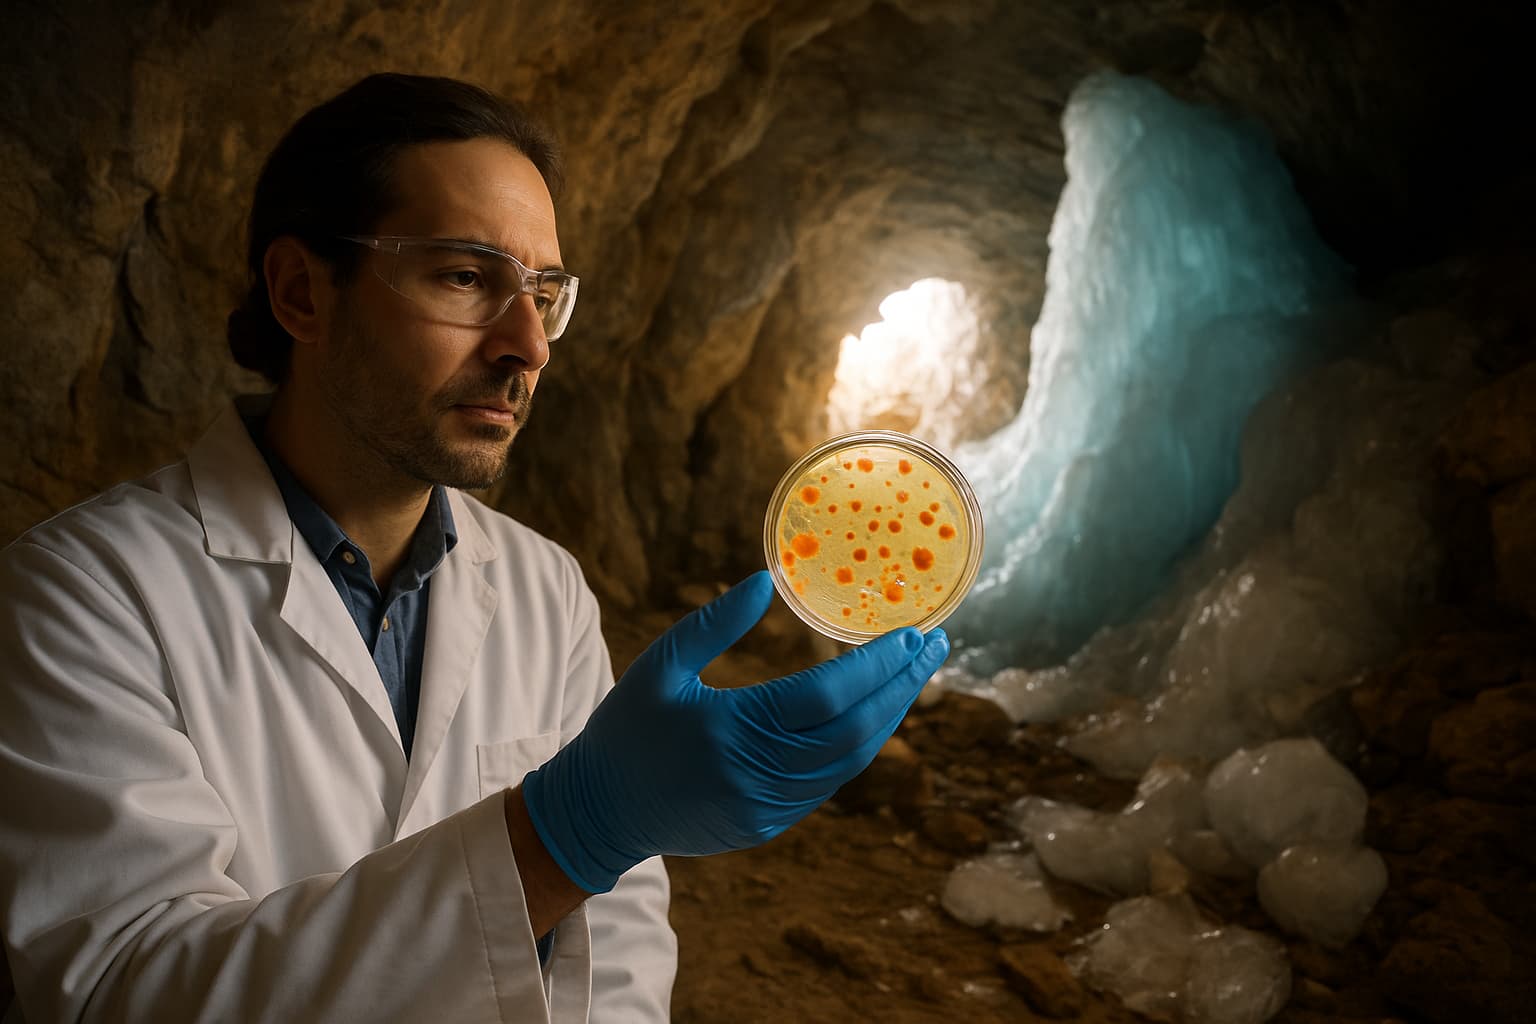
Ancient Cave Bacteria Reveals Surprising Key to Fighting Modern Superbugs

Senior Home Photoshoot Leaves Residents Feeling Decades Younger
Residents at Maplewood Court participated in a glamorous fashion photoshoot featuring vibrant wigs, colorful clothing, and bold accessories. The creative initiative, organized by facility staff members, brought joy and renewed energy to the 72 residents, including a centenarian who declared the experience made her feel 20 years younger.